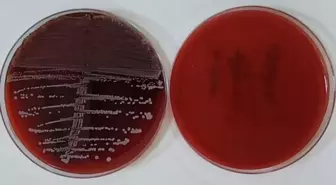
Karabük Üniversitesi'nden Enfeksiyon Riskini Azaltan Yenilikçi Implant Yöntemi

Bakteri Haberleri
Son Dakika Bakteri Haberleri
- Alpedo Dondurma'daki Bakteri İddiaları Asılsız Çıktı
- 8 yıllık çalışma ile giyilebilir kanamayı azaltan özel kumaş geliştirdi
- ABD'de Hazır Makarnadan Listeria Salgını: 6 Ölü, 25 Hastaneye Kaldırıldı
- Yapay Zeka ile Geliştirilen Virüsler, E. coli Bakterilerini Yok Edebiliyor
- Gıda Mühendisleri Uyarıyor: Okul Beslenmesinde Soğuk Zincir Tehlikesi
- Rekabet Kurumu, Konya Şeker ve 39 Firmaya Soruşturma Başlattı
- Diş çürüğüne neden olan bakteriler komşu dişe de bulaşabiliyor
- Yunanistan'da Şarbon Bakterisi Nedeniyle Hayvan Ölümleri
- Helikobakter Pilori Bakterisi Mide Sağlığını Tehdit Ediyor
- İstanbul Üniversitesi, Deniz Bakterileriyle Petrol Kirliğini Temizliyor
- Yatak Hijyeninin Önemi: Bakteri ve Mantarlar Sağlığımızı Tehdit Ediyor
- Bağırsak Florası ile Kolorektal Kanserin Erken Teşhisi Mümkün Oluyor
- Türkiye'nin biyolojik kültür koleksiyonu
- Kurban Bayramı Öncesi Salmonella Bakterisine Dikkat
- Kurban Bayramı Öncesi Salmonella Uyarısı: Hijyen Kurallarına Dikkat
- Deniz Suyunda Sıcaklık Artışı, Bakteri Riskini Yükseltiyor
- Ağın Leblebisi İçin Kimyasal Gübre Yerine Bakteri Kullanılacak
- Prof. Dr. Hamit Hancı, et ve süt ürünlerindeki ölümcül bakterilere karşı uyardı
- Beyaz Ette Ölümcül Bakteri... Gıda Mühendisleri Odası Yönetim Kurulu Üyesi Toprak'tan Uyarı
- Norovirüs nedir, belirtileri nelerdir? Norovirüs havadan bulaşır mı?